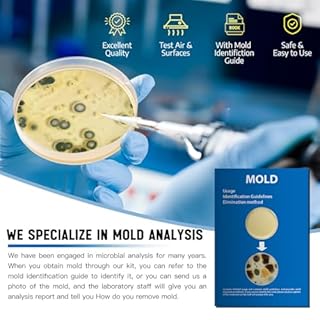
Mold Test Kit for Home -DIY Mold Testing Kit with 6 Individual Tests-Black Mold Detector-Indoor Air Quality Tester-Mold Identification Guide-Free Lab Analysis-Fast and Reliable Mold Detector at Home

10 Best Radon Air Quality Monitor in Canada
- Updated original radon detector with Bluetooth and added temperature and humidity sensors.
- Continuous monitoring of radon gas for ongoing safety, with no lab fees or wait times for results.
- The app provides graphs to observe fluctuations in radon levels, enabling proactive measures to maintain safety.
- Personalized guidance to help manage radon levels effectively and enhance homeowner confidence.
- Utilizes Airthings' trusted radon sensing technology, recommended by many professionals and home inspectors.
- Updated original radon detector with Bluetooth and added temperature and humidity sensors.
- Continuous monitoring of radon gas for ongoing safety, with no lab fees or wait times for results.
- The app provides graphs to observe fluctuations in radon levels, enabling proactive measures to maintain safety.
- Personalized guidance to help manage radon levels effectively and enhance homeowner confidence.
- Battery-operated digital radon detector for easy home monitoring without the need for an outlet.
- Long-term monitoring of radon gas is essential, as levels can vary daily.
- Generate radon self-inspection reports on demand.
- Receive initial radon level readings within 24 hours on the digital display, with no laboratory fees involved.
- Includes Airthings Corentium Home device, 3 AAA batteries, bilingual quick start guide, one-year warranty, and customer support access.
- Displays current readings as well as historical data for 1 day, 7 days, and up to 1 year, reflecting the natural fluctuations of radon gas.
- Battery-operated digital radon detector for easy home monitoring without the need for an outlet.
- Long-term monitoring of radon gas is essential, as levels can vary daily.
- Generate radon self-inspection reports on demand.
- Receive initial radon level readings within 24 hours on the digital display, with no laboratory fees involved.
- Radon is a leading cause of lung cancer in non-smokers, claiming more lives than home fires and carbon monoxide poisoning combined
- Radon levels can vary daily due to factors like weather, making continuous monitoring essential for understanding long-term exposure and health risks
- The device provides an easy-to-read color-coded air quality indicator or detailed results through a smartphone app
- Receive immediate radon level reports on your smartphone without any lab fees, and generate comprehensive radon reports via the Airthings Dashboard
- This smart radon detector operates on batteries, constantly monitoring radon gas, humidity, and temperature year-round
- The device features Smartlink functionality for 24/7 online data access through the Airthings Hub
- Radon is a leading cause of lung cancer in non-smokers, claiming more lives than home fires and carbon monoxide poisoning combined
- Radon levels can vary daily due to factors like weather, making continuous monitoring essential for understanding long-term exposure and health risks
- The device provides an easy-to-read color-coded air quality indicator or detailed results through a smartphone app
- Continuously monitors radon levels every 10 minutes for real-time data.
- Operates on 2 AA batteries with a lifespan of up to 7 years.
- Measures additional environmental factors: temperature, humidity, and atmospheric pressure.
- Features an E-Ink display with color-coded indicators for quick assessment of radon levels. Compatible with an app for detailed insights.
- Offers multiple display modes for average readings over various timeframes and supports two measurement units: Bq/m3 and pCi/L.
- Continuously monitors radon levels every 10 minutes for real-time data.
- Operates on 2 AA batteries with a lifespan of up to 7 years.
- Measures additional environmental factors: temperature, humidity, and atmospheric pressure.
- Features an E-Ink display with color-coded indicators for quick assessment of radon levels. Compatible with an app for detailed insights.
- Radon measurement is crucial as it is the second leading cause of lung cancer, with levels varying daily. The LifeBasis radon detector provides accurate long-term readings to protect your family's health.
- The LifeBasis radon detector features a high-precision semiconductor sensor for accurate radon measurements ranging from 0.09 to 1000 pCi/L (3.3 Bq/m³ - 37k Bq/m³). Initial readings appear after 6 hours, then updates occur hourly, with options to view the latest readings from different time intervals.
- Long-term monitoring is supported with the ability to view historical radon concentration data for up to 504 days. The detector saves a record every 6 hours, allowing access to 10 sets of detection results.
- Two alarm modes indicate hazardous radon levels with color-coded alerts and sound notifications. The threshold for alerts can be adjusted to align with local safety standards, enabling prompt action when necessary.
- The radon monitor is rechargeable, featuring a built-in battery that lasts up to 45 days (with the screen off), and a full charge takes 3.5 hours. Its compact design makes it suitable for various environments including homes, offices, and schools.
- A color TFT 2.0 screen and graphical interface simplify the operation of the radon tester, allowing for clear readings. Users can customize measurement units, alarm thresholds, and screen sleep settings.
- Radon measurement is crucial as it is the second leading cause of lung cancer, with levels varying daily. The LifeBasis radon detector provides accurate long-term readings to protect your family's health.
- The LifeBasis radon detector features a high-precision semiconductor sensor for accurate radon measurements ranging from 0.09 to 1000 pCi/L (3.3 Bq/m³ - 37k Bq/m³). Initial readings appear after 6 hours, then updates occur hourly, with options to view the latest readings from different time intervals.
- 300 DPI resolution ensures high clarity in display results.
- Tempered glass offers high light transmission and durability against breakage.
- Refined algorithm and new sensor design enhance accuracy in level detection.
- Battery-powered for easy installation and replacement.
- Blinking alarm feature alerts users to level surges.
- Selectable holder allows for standalone use or wall mounting.
- 300 DPI resolution ensures high clarity in display results.
- Tempered glass offers high light transmission and durability against breakage.
- Refined algorithm and new sensor design enhance accuracy in level detection.
- Battery-powered for easy installation and replacement.
- Blinking alarm feature alerts users to level surges.
- Selectable holder allows for standalone use or wall mounting.
- WiFi-enabled indoor air quality monitor measuring radon gas, particulate matter (PM2.5), carbon dioxide, VOCs, humidity, temperature, and air pressure.
- Digital radon detector, crucial for recognizing and mitigating lung cancer risks associated with radon exposure.
- Companion app for managing notifications, monitoring real-time readings, and analyzing air quality trends; includes local pollen forecasts.
- User-friendly, battery-operated design allows for easy setup and relocation; features a customizable eInk display for quick readings.
- Package includes Airthings View Plus, 6 AA batteries, Quick Start Guide, and a 5-year warranty with customer support.
- WiFi-enabled indoor air quality monitor measuring radon gas, particulate matter (PM2.5), carbon dioxide, VOCs, humidity, temperature, and air pressure.
- Digital radon detector, crucial for recognizing and mitigating lung cancer risks associated with radon exposure.
- Companion app for managing notifications, monitoring real-time readings, and analyzing air quality trends; includes local pollen forecasts.
- Complies with performance standards for high-precision radon detection, providing accurate results within 24 hours; recommended testing duration for optimal accuracy is 7 days or more.
- Features a clear LCD display showing short-term and long-term radon levels without the need for apps or internet access.
- Maintains consistent data tracking with built-in data retention, automatically resuming recordings after power interruptions within 4 hours.
- User-friendly and ready out of the box; operates with low power consumption for up to 24 months on a single battery, ideal for seniors.
- Easily relocatable with a reset button for reusability; designed for convenient use in various rooms without extra devices.
- Complies with performance standards for high-precision radon detection, providing accurate results within 24 hours; recommended testing duration for optimal accuracy is 7 days or more.
- Features a clear LCD display showing short-term and long-term radon levels without the need for apps or internet access.
- Maintains consistent data tracking with built-in data retention, automatically resuming recordings after power interruptions within 4 hours.
- Real-time detection of PM1.0, PM2.5, PM10, CO2, TVOC, HCHO, temperature, and humidity with alert function for air quality index (AQI).
- User-friendly operation with one-button start, easy switching between °C/°F, and simple silencing of alerts.
- High-precision sensors provide air quality updates every 3 seconds, displayed on a clear, advanced color screen.
- Up to 5 hours of use on a full charge, with fast charging via included Type-C cable and adapter.
- Stylish design and versatile mounting options make it suitable for various environments, including homes, cars, and offices.
- Real-time detection of PM1.0, PM2.5, PM10, CO2, TVOC, HCHO, temperature, and humidity with alert function for air quality index (AQI).
- User-friendly operation with one-button start, easy switching between °C/°F, and simple silencing of alerts.
- High-precision sensors provide air quality updates every 3 seconds, displayed on a clear, advanced color screen.
- Up to 5 hours of use on a full charge, with fast charging via included Type-C cable and adapter.
- Real-time detection of PM1.0, PM2.5, PM10, CO2, TVOC, HCHO, temperature, and humidity with alert function for air quality index (AQI).
- User-friendly operation with one-button start, easy switching between °C/°F, and simple silencing of alerts.
- High-precision sensors provide air quality updates every 3 seconds, displayed on a clear, advanced color screen.
- Up to 5 hours of use on a full charge, with fast charging via included Type-C cable and adapter.
- Stylish design and versatile mounting options make it suitable for various environments, including homes, cars, and offices.
- Real-time detection of PM1.0, PM2.5, PM10, CO2, TVOC, HCHO, temperature, and humidity with alert function for air quality index (AQI).
- User-friendly operation with one-button start, easy switching between °C/°F, and simple silencing of alerts.
- High-precision sensors provide air quality updates every 3 seconds, displayed on a clear, advanced color screen.
- Up to 5 hours of use on a full charge, with fast charging via included Type-C cable and adapter.
How We Estimate & Rank
We make shopping simple by hand-picking the top 10 Radon Air Quality Monitor just for you. Our team focuses on what’s available right now, what’s popular with other shoppers, and, most importantly, what’s most relevant to your search. We cover leading brands such as AIRTHINGS, Aranet, Life Basis, CRADTEC, X-Sense, and other trusted names in this category. By filtering out the noise, we ensure you only see high-quality options that actually meet your needs. It’s all the best finds, minus the endless scrolling!
Final Recommendations
We’ve selected three standout options to make your choice easier
Our overall winner is Airthings 325 Corentium Home 2 Smart Digital Radon Detector by AIRTHINGS, earning top marks for its balanced combination of quality, performance, and price.


The best value for most shoppers is AIRTHINGS Corentium Home by AIRTHINGS, earning consistently positive feedback for its performance and accessible pricing.

The best deal right now for Indoor Air Quality Meters is Professional Indoor Air Quality Monitor with AQI Alerts by AirWhisper, now at its lowest price of $89.99.